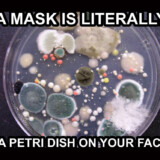

…………….
Return To Main COVID-19 Resource Page
…………….
The Lighter Side Of COVID-19
……………….
The Lighter Side Of COVID-19: Rumble Video Playlist
……………….
How The World Reacted The Past Three Years…
……………….
Vaxxed Versus Unvaxxed – Which Is Better? Getting mRNA Juiced Or Relying On Natural Immunity?
…………….
Face Mask Madness By @SunfellowCovid19 On Rumble
…………….
Just Take The Jab! Or Else…
………………..
COVID-19 Memes
……………….
9 Powerful Verses In The Bible That Support Vaccination
………………..
Covid-19 Vaccination Workaround
………………..
Unvaccinated Men In 2022
………………..
Petition To Arrest & Jail All Unvaccinated Adults…
………………..
Trust The Government. Trust The Media. Don’t Question Anything.
……………….
Over-The-Top Mask Wearing & Social Distancing
……………….
Hello (from the Inside) An Adele Parody by Chris Mann
……………..
Trust The Experts
……………..
…………….
Return To Main COVID-19 Resource Page
…………….